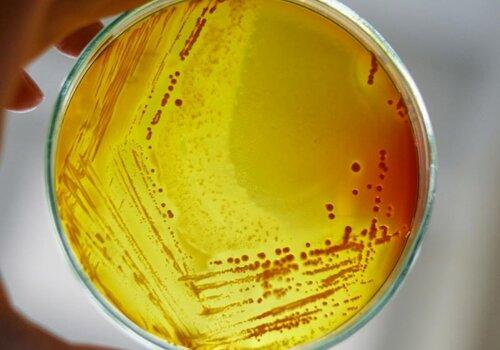
Isolement de bactéries sur une gélose en boite de Pétri

Des hommes, des animaux et des microbes
Découvrez les multiples facettes de la recherche en infectiologie
- Sciences de la vie et de la santé
Les bactéries, les virus et les parasites sont des agents pathogènes qui peuvent être spécifiques d’un hôte (animal ou homme) ou se transmettre de l’un à l’autre. Comment l’hôte réagit-il face à ces agresseurs ? Comment les agents pathogènes échappent-ils aux systèmes de défense de l’hôte ? Comment résistent-ils aux médicaments ?
Venez découvrir les modèles développés, les études et les analyses réalisées au sein de l’unité « Infectiologie et Santé Publique » (INRAE-Université de Tours) pour répondre à ces questions (et bien d’autres). Vous ferez connaissance avec le monde microbien et vous pourrez vous essayer à certaines de nos activités quotidiennes : observer au microscope, faire des dilutions, compter des colonies bactériennes, lire un antibiogramme et … bien se laver les mains !
Informations pratiques
Publics concernés
6 - 11 ans, 11 - 15 ans, 15 - 18 ans, 18 - 25 ans, 25 ans et +

